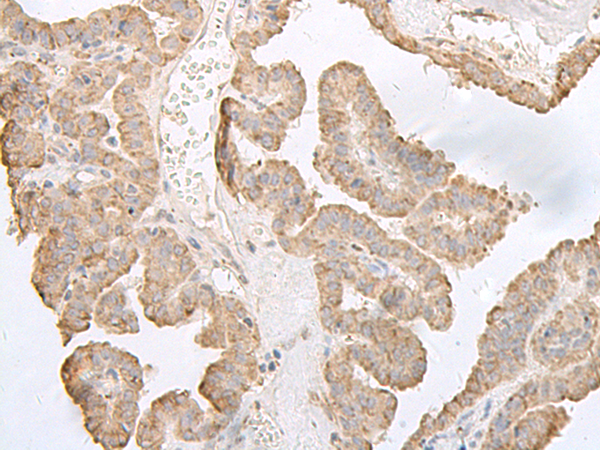

中文名稱: 兔抗PFKM多克隆抗體
英文名稱: Anti-PFKM rabbit polyclonal antibody
別 名: phosphofructokinase, muscle; GSD7; PFK1; PFKA; PFKX; PFK-1; ATP-PFK; PPP1R122
相關(guān)類別: 一抗
儲(chǔ) 存: 冷凍(-20℃)
宿 主: Rabbit
抗 原: PFKM
反應(yīng)種屬: Human, Mouse, Rat
標(biāo) 記 物: Unconjugate
克隆類型: rabbit polyclonal
技術(shù)規(guī)格
|
Background: |
Three phosphofructokinase isozymes exist in humans: muscle, liver and platelet. These isozymes function as subunits of the mammalian tetramer phosphofructokinase, which catalyzes the phosphorylation of fructose-6-phosphate to fructose-1,6-bisphosphate. Tetramer composition varies depending on tissue type. This gene encodes the muscle-type isozyme. Mutations in this gene have been associated with glycogen storage disease type VII, also known as Tarui disease. Alternatively spliced transcript variants have been described. |
|
Applications: |
ELISA, IHC |
|
Name of antibody: |
PFKM |
|
Immunogen: |
Fusion protein of human PFKM |
|
Full name: |
phosphofructokinase, muscle |
|
Synonyms: |
GSD7; PFK1; PFKA; PFKX; PFK-1; ATP-PFK; PPP1R122 |
|
SwissProt: |
P08237 |
|
ELISA Recommended dilution: |
5000-10000 |
|
IHC positive control: |
Human liver cancer |
|
IHC Recommend dilution: |
40-200 |

購(gòu)物車
幫助
021-54845833/15800441009
